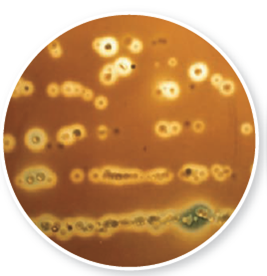
From chapter 3, figure 3.3 a. What chemical is the organism in this illustration producing How does this add to an organism's pathogenicity Figure 3.3 Examples of enriched media. (a) Blood agar plate growing bacteria from the human throat. Note that this medium also differentiates among colonies by the zones of hemolysis (clear areas) they may show.

Microbiology: A Systems Approach 4th Edition by Marjorie Kelly Cowan
Edition 4ISBN: 978-0073402437
Microbiology: A Systems Approach 4th Edition by Marjorie Kelly Cowan
Edition 4ISBN: 978-0073402437 Exercise 46
From chapter 3, figure 3.3 a. What chemical is the organism in this illustration producing How does this add to an organism's pathogenicity
Figure 3.3 Examples of enriched media. (a) Blood agar plate growing bacteria from the human throat. Note that this medium also differentiates among colonies by the zones of hemolysis (clear areas) they may show.

Figure 3.3 Examples of enriched media. (a) Blood agar plate growing bacteria from the human throat. Note that this medium also differentiates among colonies by the zones of hemolysis (clear areas) they may show.
Explanation
The organism is producing hemolysin. Hem...
Microbiology: A Systems Approach 4th Edition by Marjorie Kelly Cowan
Why don’t you like this exercise?
Other Minimum 8 character and maximum 255 character
Character 255

